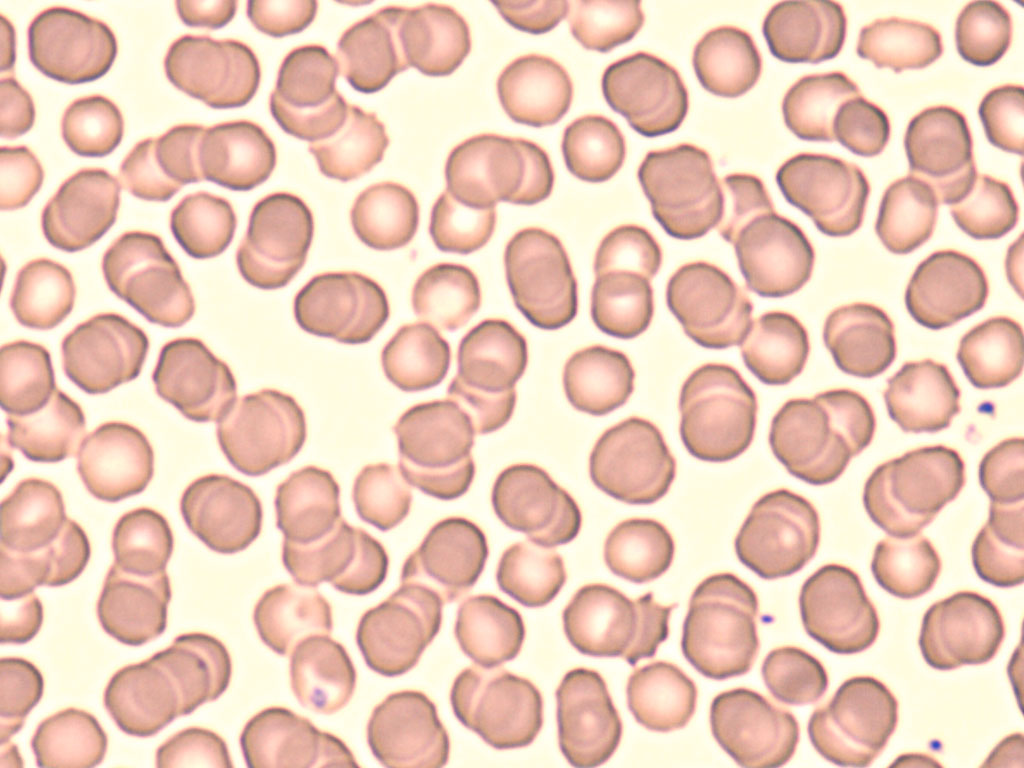
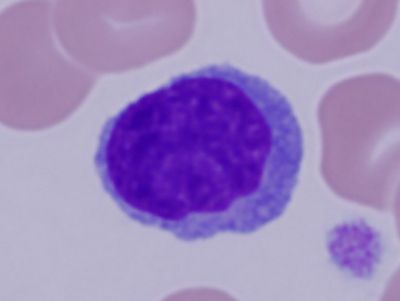
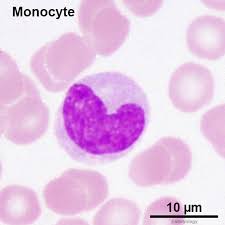
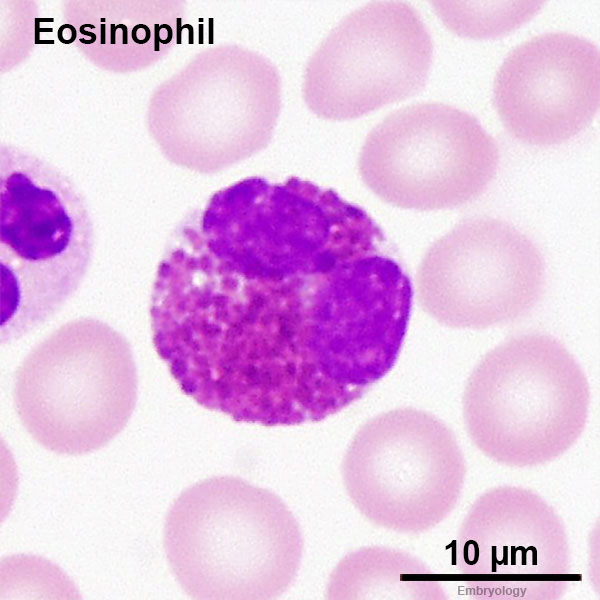
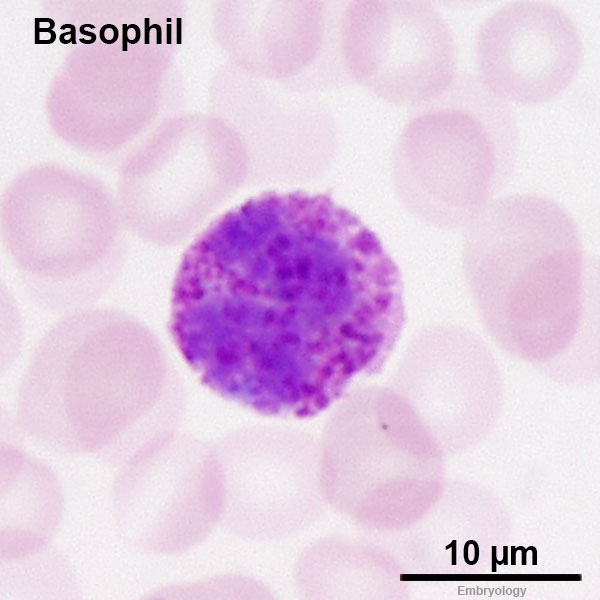
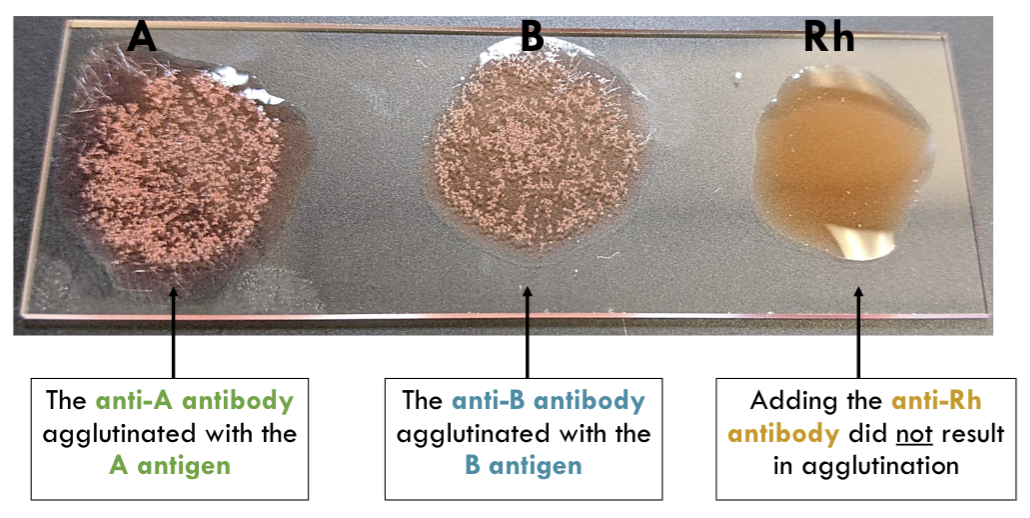

1/67
*Does not include heart anatomy or fetal pig circulation anatomy
Name | Mastery | Learn | Test | Matching | Spaced | Call with Kai |
|---|
No analytics yet
Send a link to your students to track their progress
Erythrocyte
Lack of nucleus
Lymphocyte
Large, dark-staining nucleus
Little cytoplasm
Agranular
Neutrophil

Multilobed (3-5 segments) nucleus
Granular
Monocyte
Horseshoe-shaped nucleus
Agranular
Eosinophil
Two-lobed nucleus
Granular
More orange-red compared to basophils
Basophil
Two-lobed, difficult to see nucleus
Granular
More purple compared to eosinophils
Which lymphocytes are granulocytes?
Neutrophils, eosinophils, basophils
Which lymphocytes are agranulocytes?
Lymphocytes, monocytes
Which cells make up the buffy coat?
White blood cells (leukocytes) and platelets
Which two blood vessels have an internal and external elastic membrane? Why?
The aorta and pulmonary trunk, to withstand higher pressures from blood leaving the heart
Artery

Thick tunica intima
Has external elastic membrane
Often filled with red blood cells (red middle_
Layers of artery, outermost to innermost
Tunica externa → external elastic membrane → tunica media → tunica intima → endothelium → lumen
Vein

Collapsed lumen
Lack of external elastic membrane
Layers of vein, outermost to innermost
Tunica externa → tunica media → tunica intima → endothelium → lumen
What cell type is the tunica intima?
Simple squamous epithelium
Frog intestine

Lots of surface area in the lumen for nutrient absorption
Layers of frog intestine, from outermost to innermost
Longitudinal smooth muscle → circular smooth muscle → connective tissue → columnar epithelial tissue → lumen → villi
Lung bronchus

Innermost layer has ridges surrounding the lumen
Supported by smooth muscle and hyaline cartilage (with lacunae)
Lung bronchiole

Not surrounded by cartilage
Smaller than bronchus

Lung alveoli and capillaries

Red lines are capillaries filled with red blood cells
White gaps in between capillaries are the alveoli
Liver portal triad

Has a hepatic portal vein, hepatic artery, and bile duct

Which cell type in the liver performs fat metabolism?
Hepatocytes
How many cells are in a morula?
16 cells
Layers of gastrula, from outermost to innermost
Ectoderm → mesoderm→ endoderm
What is the fluid-filled cavity of a blastocyst called?
Blastocoel
Morula

Packed cluster of 16 cells, looks like raspberries
Blastocyst

Central cavity surrounded by an epithelial layer (hollow ball of cells)
Gastrula

Contains an ectoderm, mesoderm, and endoderm (outermost to innermost)
Has one pore
Sperm

Human egg/ovum

Has a relatively central nucleus
What is the normal pH of urine?
4.5 to 8.0, with an average pH of about 6.5
Albuminuria
Presence of albumin in the urine. May be caused by damage to the kidneys, such as glomerulonephritis
Proteinuria
Presence of excess protein in the urine
Ketonuria
Presence of high levels of ketone bodies (acetone, acetoacetate) in the urine.
How does ketosis affect urine pH?
Ketosis lowers urine pH, through the excretion of excess ketone bodies which are acidic byproducts of fat metabolism
Glycosuria
Presence of excessive glucose in the urine. Indicates diabetes mellitus
Type 1 Diabetes mellitus
A condition where the insulin-producing cells in the pancreas are destroyed
Effects of Type 1 Diabetes mellitus on urine composition
Leads to glycosuria, ketonuria, and lower urine pH (more acidic) due to ketoacidosis
Effects of Type 1 Diabetes mellitus on urine production, thirst, and hunger
Leads to polyuria, polydipsia, and polyphagia
Type 2 Diabetes mellitus
A condition where the body’s cells are resistant to insulin. Leads to glycosuria, but pH remains normal
Polyuria
Excess urine production, with a low solute concentration. Indicates diabetes insipidus
Diabetes inspidus
Improper water balance regulation, leading to polydipsia and polyuria. Leads to large volmes of diluted urine
What type of diet often leads to presence of ketones in urine?
Keto diets, or low carb diets. often lead to ketones in the urine because the body has to create ketone bodies from fat through ketosis
Ketone body
Product of fat → ketone body metabolism, produced when the body lacks glucose. Alternative fuel source
Negative and positive colors for Benedict’s reagent (detects GLUCOSE)

Negative → BLUE
Positive: → GREEN (low), YELLOW (medium), ORANGE (high conc.)

Negative and positive colors for Biuret reagent (detects PROTEIN)


Negative and positive colors for Ferric chloride (detects acetoacetic acid ketone)
Negative → YELLOW
Positive: → LIGHT BROWN to BLACK
Immunoprecipitate

Insoluble solid that forms when soluble antigens and antibodies link together
White line on agar

Components of petri dish immunoprecipitate experiment
Central well with antigen (rubella)
1 positive control well (anti-rubella serum)
1 negative control well (normal serum)
X number of patient wells
Agglutination

Clumping of particles such as bacteria or RBC’S, caused by antibodies cross-linking antigens on the surfaces of these particles
What causes agglutination in blood?
When antibodies and antigens of the same type are present in the blood at the same time, leading to clumping
Under normal conditions, do people with Rh- blood have anti-Rh antibodies present in their plasma?
No, they typically do not have anti-Rh antibodies in their plasma
When can a person with Rh- blood exhibit anti-Rh antibodies in their plasma?
When Rh- blood comes into contact with Rh+ blood. E.g. during labor, the fetus’ Rh+ blood mixes with the mother’s Rh- blood
What in the blood determines blood type?
The antigens on the surface of red blood cells determines blood type. E.g. A antigen = type A blood
In a petri dish, what is the interaction between an antibody and antigen called?
It is called an immunoprecipitate, and creates a white line on the agar
How strongly do inorganic electrolytes conduct electricity?
They conduct electricity very strongly, because they typically dissociate completely into ions which act as mobile charge carriers
How strongly do organic electrolytes conduct electricity?
They weakly conduct electricity, because they have covalent bonds which only weakly dissociate into ions; leaving few mobile charge carriers
Electrolyte
A substance that dissociates into ions when dissolved in water, allowing the solution to conduct electricity. Typically ionic compounds
What type of bonds do electrolytes typically have?
They typically have ionic bonds
What type of bonds do nonelectrolytes typically have?
They typically have covalent bonds
Nonelectrolyte
A substance that dissolves in water without dissociating into ions, making a solution that does not conduct electricity. Typically covalent compounds
How does dissociation indicate the strength of an acid/base?
Strong acids/bases almost completely dissociate, while weak acids/bases only partially dissociate
Electrolysis (in copper wire/solution experiment)
The formation of bubbles in a conducting solution, where the solution conducts electricity
If “bubbles” DO form when the copper wire enters the solution, what is in the solution?

If bubbles DO form, the solution contains electrolytes with dissociated ions. E.g. NaCl, KOH

If “bubbles” DO NOT form when the copper wire enters the solution, what is in the solution?
If bubbles do not form, the solution contains nonelectrolytes. E.g. acetone, fructose, alcohol

Is water an electrolyte?
No. Water is a non-electrolyte
What structures does a female fetal pig have that a male fetal pig does not?
They have ovaries, uterine horns, genital papilla (external) and a vagina
How does urethral length compare in male vs female fetal pigs?
Male fetal pigs have much longer urethras compared to females